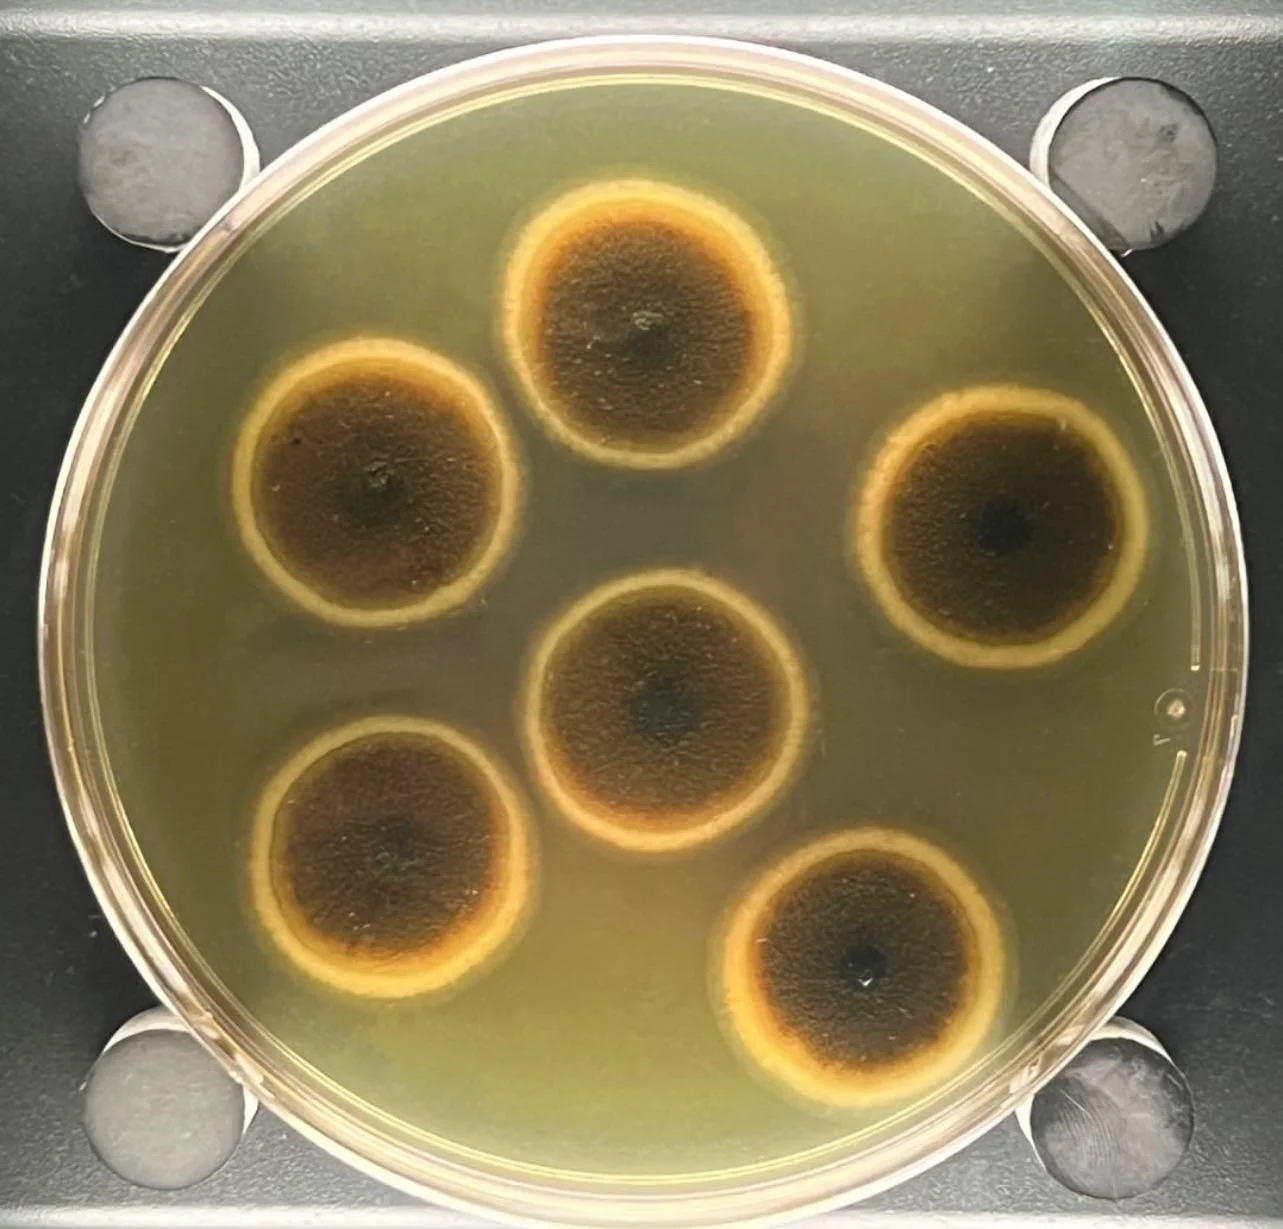

Hongos que podrían sobrevivir en Marte: qué dice la ciencia sobre la vida terrestre en el espacio
Una nueva investigación constata que algunos hongos terrestres pueden resistir condiciones similares a las de Marte, lo que desafía lo que creíamos sobre los límites de la vida. El hallazgo reabre el debate sobre la contaminación planetaria y hasta qué punto estamos llevando vida de la Tierra al espacio en nuestras misiones.
Por Enrique Coperías, periodista científico
Recreación artística de un paisaje marciano con hongos terrestres creciendo sobre una roca, una hipótesis visual basada en su sorprendente resistencia a condiciones extremas del espacio. Crédito: IA-Nano Banana 2-RexMolón Producciones
Un hallazgo clave para la exploración espacial y la astrobiología
En los entornos más estériles de la Tierra, donde la limpieza es casi obsesiva y cada partícula cuenta, prospera una vida inesperada. No hablamos de selvas ni de océanos, sino en salas blancas de la NASA, donde se ensamblan naves espaciales destinadas a explorar otros mundos.
Allí, en condiciones diseñadas para eliminar cualquier rastro biológico, algunos microorganismos no solo resisten:, sino que parecen prepararse para el viaje espacial.
Un nuevo estudio revela que ciertos hongos resistentes hallados en estos entornos ultralimpios podrían sobrevivir no solo al viaje espacial, sino también a las duras condiciones de Marte. El hallazgo reabre un viejo debate en la exploración espacial: ¿somos realmente capaces de evitar contaminar otros planetas con vida terrestre?
Los autores de la investigación, publicada en la revista Applied and Environmental Microbiology, analizóaron veintinueve microorganismos —principalmente hongos— aislados de instalaciones donde se ensamblan sondas espaciales. De ellos, veintitrés fueron capaces de sobrevivir a una intensa radiación ultravioleta, una de las amenazas más letales fuera de la atmósfera terrestre. Pero uno destacó por encima de todos: Aspergillus calidoustus, un hongo microscópico cuya resistencia desafía las expectativas científicas.
Marte no es un lugar hospitalario
Para cualquier forma de vida terrestre, Marte representa un entorno extremo. Su atmósfera marciana es tenue, compuesta en su mayoría por dióxido de carbono, con una presión superficial de apenas 6 milibares, menos del 1% de la terrestre. Además, la radiación ultravioleta en Marte es hasta diez veces más intensa que en la Tierra, y la temperatura media ronda los –60 °C.
A esto se suma la sequedad extrema y la ausencia de protección magnética significativa frente a la radiación cósmica, el flujo de partículas de alta energía, principalmente protones y núcleos atómicos, que viajan por el espacio a gran velocidad y proviene sobre todo del Sol, las explosiones de estrellas, como las supernovas, y otras fuentes del universo profundo. Durante décadas, estas condiciones se han considerado prácticamente esterilizantes.
Sin embargo, la biología lleva tiempo mostrando grietas en esa certeza. Algunos microorganismos extremófilos, especialmente esporas bacterianas y ciertos hongos, han demostrado tolerar la radiación, la desecación y las temperaturas extremas. La pregunta ya no es si pueden resistir algunos de estos factores, sino si pueden sobrevivir a todos ellos combinados.
El experimento: cómo se simuló Marte en la Tierra
Para responder a esta cuestión, el equipo de investigadores, dirigido por Kasthuri Venkateswaran, microbiólogo del Jet Propulsion Laboratory (Estados Unidos), y Andreas Elsaesser, biofísico de la Universidad de Berlín (Alemania), recrearon en laboratorio un entorno marciano completo: radiación solar simulada, atmósfera rica en CO₂, baja presión, suelo similar al regolito marciano y temperaturas de hasta –60 °C. A esto añadieron otros factores propios de una misión espacial, como la radiación ionizante acumulada durante meses de viaje.
El objetivo era ambicioso: evaluar, de principio a fin, qué le ocurriría a estos microorganismos desde el momento en que abandonan la Tierra hasta su hipotética llegada a Marte.
Los resultados fueron sorprendentes. Aspergillus calidoustus fue capaz de sobrevivir a veinticuatro horas continuas de radiación solar marciana simulada, con una reducción de su población, pero sin desaparecer por completo de la muestra. También resistió meses de exposición a radiación similar a la que experimentaría una nave en tránsito hacia el planeta rojo.
Incluso los métodos estándar de esterilización de naves espaciales —basados en calor seco— no lograron eliminarlo por completo en condiciones habituales. Solo temperaturas más elevadas de lo normal consiguieron erradicarlo totalmente .
Colonias del hongo Aspergillus calidoustus cultivadas en laboratorio, una especie capaz de resistir condiciones extremas similares a las del espacio y Marte. Cortesía: world_of_microbiology12
El impacto del suelo marciano
Paradójicamente, ningún factor individual resultó letal por completo para este hongo. Ni la radiación, ni el frío, ni la atmósfera marciana por sí solos lograron destruirlo. Fue la combinación simultánea de radiación intensa y temperaturas extremas lo que finalmente eliminó toda viabilidad celular. Según los autores, la letalidad solo se alcanzó cuando se combinaron de forma sinérgica la radiación con el enfriamiento extremo a -60°C.
Este hallazgo es muy importante, ya que sugiere que, en ciertas condiciones, por ejemplo, zonas protegidas de la radiación directa o con microambientes más templados, algunos microorganismos podrían sobrevivir en Marte.
Además, los experimentos mostraron que el suelo marciano simulado podía ejercer un efecto protector limitado en algunos casos, y actuar como escudo parcial frente a la radiación. Aunque este efecto no fue consistente, abre la puerta a escenarios en los que el subsuelo marciano podría ser más habitable de lo que se pensaba.
Por otro lado hay que decir que la resistencia de estos hongos a condiciones extremas no es gratuita; conlleva un alto coste físico. El análisis mediante microscopía electrónica de barrido permitió observar cómo el entorno marciano altera la morfología de dichas esporas. Tras 1.440 minutos de exposición a estas condiciones ultraagresivas, muchas de las conidias presentaban deformaciones, grietas y rupturas. Sin embargo, a pesar de estos daños estructurales, la viabilidad de algunas células se mantuvo, lo que indica que, para este hongo, un cuerpo maltrecho es preferible a una aniquilación total
Un problema para la exploración espacial
El descubrimiento tiene implicaciones profundas para la llamada protección planetaria, el conjunto de normas destinadas a evitar la contaminación biológica de otros mundos.
Actualmente, los protocolos de limpieza de naves espaciales se centran principalmente en eliminar esporas bacterianas, consideradas tradicionalmente las formas más resistentes de vida y que funcionan como un modo de hibernación que les permite permanecer inactivas hasta que el entorno vuelve a ser favorable. Pero este estudio sugiere que los hongos —y en particular sus esporas, llamadas conidios— pueden ser igual o incluso más resistentes.
Esto plantea un problema incómodo: si estos organismos sobreviven al viaje y llegan al planeta rojo, podrían confundirse con vida extraterrestre en futuras misiones. O peor aún, podrían colonizar nichos locales y alterar un ecosistema que intentamos estudiar en su estado original.
🗣️ «Las esporas fúngicas han sido relativamente ignoradas en las estrategias de descontaminación», advierten los autores del estudio . Y eso podría ser un error. Y añaden: «Este trabajo proporciona un conocimiento fundamental sobre la tolerancia de la vida a extremos ambientales tanto en la Tierra como más allá».
Más allá del espacio: implicaciones en la Tierra
Aunque el contexto es espacial, las conclusiones del estudio también tienen consecuencias en la Tierra. Los mismos mecanismos que permiten a estos hongos resistir el espacio los hacen peligrosos en otros ámbitos.
Algunas especies del género Aspergillus son conocidas por su resistencia a procesos de esterilización industrial utilizados en las industrias alimentariay farmacéutica. También pueden causar infecciones respiratorias, especialmente en personas con sistemas inmunitarios debilitados.
Comprender cómo sobreviven a condiciones extremas podría ayudar a desarrollar mejores métodos de control y desinfección, tanto en hospitales como en industrias críticas.
Un técnico de la NASA trabaja en una sala blanca durante el ensamblaje del róver VIPER en Houston, un entorno ultralimpio donde pueden sobrevivir microorganismos resistentes como los hongos estudiados. Cortesía: NASA/Johnson Space Center
Astrobiología: hay que redefinir los límites de la vida
El estudio refuerza una idea cada vez más presente en astrobiología: la vida es extraordinariamente adaptable. Lo que antes se consideraba inhóspito puede no serlo tanto para ciertos organismos.
Durante años, la posibilidad de vida en Marte se ha centrado en la búsqueda de formas autóctonas, ya sean actuales o fósiles. Pero este trabajo introduce una dimensión diferente: la vida terrestre como posible polizón interplanetario.
No se trata de ciencia ficción. Las misiones actuales y futuras, como el retorno de muestras marcianas, aumentan el riesgo de intercambio biológico entre planetas. Y cada descubrimiento sobre la resistencia de los microorganismos obliga a revisar nuestras precauciones.
Un desafío para el futuro
La exploración de Marte se encuentra en un momento crucial, sobre todo después del éxito de Artemis II, la primera misión tripulada a la Luna en más de medio siglo. Las agencias espaciales planean misiones más ambiciosas, que incluyen la eventual presencia humana en el planeta rojo. Pero con cada paso adelante, también crece la responsabilidad.
Si la vida terrestre puede sobrevivir en Marte, aunque sea de forma limitada, la línea entre exploración y contaminación se vuelve difusa. Y la pregunta deja de ser técnica para convertirse en ética: ¿tenemos derecho a llevar nuestra biología a otros mundos?
🗣️ «Esto no significa que sea probable que se produzca una contaminación de Marte, pero nos ayuda a cuantificar mejor los posibles riesgos de supervivencia microbiana», afirma Venkateswaran, que fue científico sénior del Grupo de Biotecnología y Protección Planetaria (BPP) del Laboratorio de Propulsión a Chorro de la NASA. El grupo aplica las políticas de la NASA en diversas misiones para evitar la contaminación cruzada extraterrestre con microbios terrestres, y viceversa. «Los microorganismos pueden poseer una resistencia extraordinaria a las tensiones ambientales».
Por ahora, los hongos de las salas blancas de la NASA nos recuerdan que, incluso en los lugares más controlados, la vida encuentra la manera de persistir. Y que quizá Marte no esté tan lejos de ser un lugar habitable como creíamos.▪️(21-abril-2026)
EXPLORACIÓN LUNAR
Éxito histórico de la misión Artemis II de la NASA
PREGUNTAS&RESPUESTAS: Hongos y Marte
🍄🟫 ¿Pueden los hongos sobrevivir en Marte?
Sí, algunos hongos pueden sobrevivir en condiciones simuladas de Marte, especialmente si no se combinan todos los factores extremos.
🍄🟫 ¿Qué microorganismos son más resistentes?
Hongos del género Aspergillus, especialmente Aspergillus calidoustus.
🍄🟫 ¿Existe riesgo de contaminar Marte?
Sí. Este estudio demuestra que ciertos microorganismos pueden viajar y sobrevivir, lo que representa un riesgo real.
🍄🟫 ¿Cómo se evita la contaminación planetaria?
Mediante protocolos de esterilización, aunque actualmente podrían necesitar mejoras para incluir hongos resistentes.
🍄🟫 ¿Esto significa que hay vida en Marte?
No. El estudio habla de vida terrestre capaz de sobrevivir allí, no de vida marciana autóctona.
ASTROBIOLOGÍA Y VIDA EXTRATERRESTRE
El suelo de Marte pone a prueba a los osos de agua: claves para sembrar de vida el planeta rojo
Ni siquiera los organismos más resistentes de la Tierra salen indemnes al contacto con el regolito marciano. Un estudio con tardígrados u osos de agua pone sobre la mesa qué obstáculos químicos esconde el polvo rojo y qué habría que transformar para llevar vida a Marte.
Información facilitada por la Sociedad Estadounidense de Microbiología
Fuente: Chander A. M. , Burr D. J., Wipf S., Nitsche R, Fujimura G., Schubert W., Singh N. K., Bell J. J., Brandl A., Weil M. M., Elsaesser A., Venkateswaran K. 0. Survival of NASA-cleanroom microbial isolates under simulated space and Martian conditions.Applied and Environmental Microbiology (2026).https://doi.org/10.1128/aem.02065-25